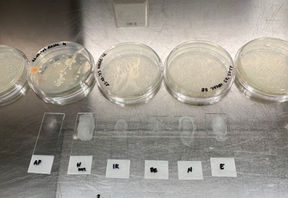

SECOND
SKIN
The human as a microcosmos
𝙁𝙪𝙩𝙪𝙧𝙚 𝙁𝙤𝙤𝙙 𝙖𝙣𝙙 𝙀𝙖𝙩𝙞𝙣𝙜 𝙋𝙧𝙖𝙘𝙩𝙞𝙘𝙚𝙨: 𝙈𝙞𝙘𝙧𝙤𝙗𝙞𝙤𝙢𝙚-𝘾𝙚𝙣𝙩𝙧𝙞𝙘 𝘿𝙞𝙣𝙞𝙣𝙜
SECOND SKIN focuses on understanding the intertwined relationship between the human body and its microbiome to explore possible future microbiome-centric eating practices, where we consider human beings as an ecology providing living space and food for the microbiota rather than seeing the body as an independent entity.
The human body is an ecosystem hosting billions of microorganisms (e.g. bacteria, archaea, fungi and viruses) on the internal and external surfaces of the body. The total number of microorganisms in the human microbiome exceeds nearly ten times the number of human cells and surpasses more than 200 times the number of human genes.

Recent studies on human body have revealed that our growth and development are not solely dictated by our own genes but also significantly influenced by this microbiome habituated in our bodies since our birth. We have an intertwined relationship with our microbiome in that we constantly regulate the composition and number of microorganisms through our diet, lifestyle and habits, and the changes in the microbiome inevitably cause alterations in our functioning, emotional state, and behaviour.
Exploring the Microbiome I Microbiome
cultivation
experiments
The future alternative food and eating practices are prominent areas in the current research and design endeavours. However, to date, the human microbiome and its effect on the human body has not been taken into account in the process of designing possible future eating practices, including eating rituals and tools, although our diet style serves as a potent force reshaping the microbiome.
But, how would this new awareness about the human body that decentering our ownership of our body and perceiving the human body as an ecology affect our eating behaviour and practices?

Second Skin project is funded by CARADT, (Centre of Applied Research for Art, Design and Technology). It will be exhibited in St. Joost School of Art & Design in Den Bosch in March 2025 as an XR exhibition.
The research conducted for the Second Skin project led to the development of the performative, multisensory XR experience ‘Microbiome Restaurant’ project, developed in collaboration with Marcel van Brakel, founder of the studio Polymorf.

Acknowledgement:
I appreciate the help and guidance of Serena Buscone during the microbiome experiments at CARADT, Material Incubator.
Special thanks to Dr. Natallia E. Uzunbajakava for sharing her expertise and our inspiring conversations.
And, the greatest thanks to Wouter Meys for his support and belief in the project.